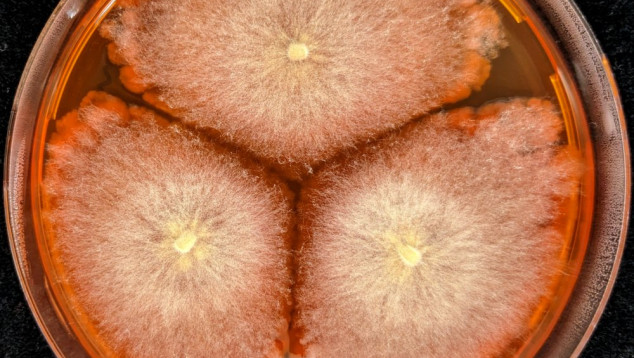
Workpackages

Promise II

Promoting Root Microbes for Integrated Striga Eradication
In Sub-Saharan Africa, many farmers face challenges accessing affordable resources to protect crops against pests and diseases, and ensuring stable crop yields for food, feed and fiber. While natural resources and fertile soils are becoming scarcer every day, feeding a growing global population will require novel and sustainable strategies to increase agricultural production. Nature offers potential allies that can help us enhance food production with less fertilizers and harmful pesticides. These partners are beneficial microbes. All life depends on them to provide many essential ecosystem services. How exactly can these microbial partners help?
Our aim is to engineer soil and plant microbiomes to enhance crop productivity in Sub-Saharan Africa. Specifically, we will explore and harness the functional potential of soil- and plant-associated microbes (bacteria and fungi) to minimize yield losses caused by Striga, a root parasitic weed that adversely affects many cereal crops all over the Sub-Saharan region.
Latest News
-
Promise II - First Annual Meeting
Annual Meeting 2025
-
International Parasitic Plant Society
In Promise II, we are in close relation with the International Parasitic Plant Society, as we are both advancing in scientific research regarding parasitic plants. IPPS's goal is to increase the understanding of these amazing plants, providing a platform for exchange among and beyond the scientific community as well as helping decrease the crop damage inflicted by weedy parasitic plants. If you want to know more about parasitic plants, you are cordially invited to become a member

-
New Publication
The soil microbiome modulates the sorghum root metabolome and cellular traits with a concomitant reduction of Striga infection
Events
Er zijn geen evenementen.